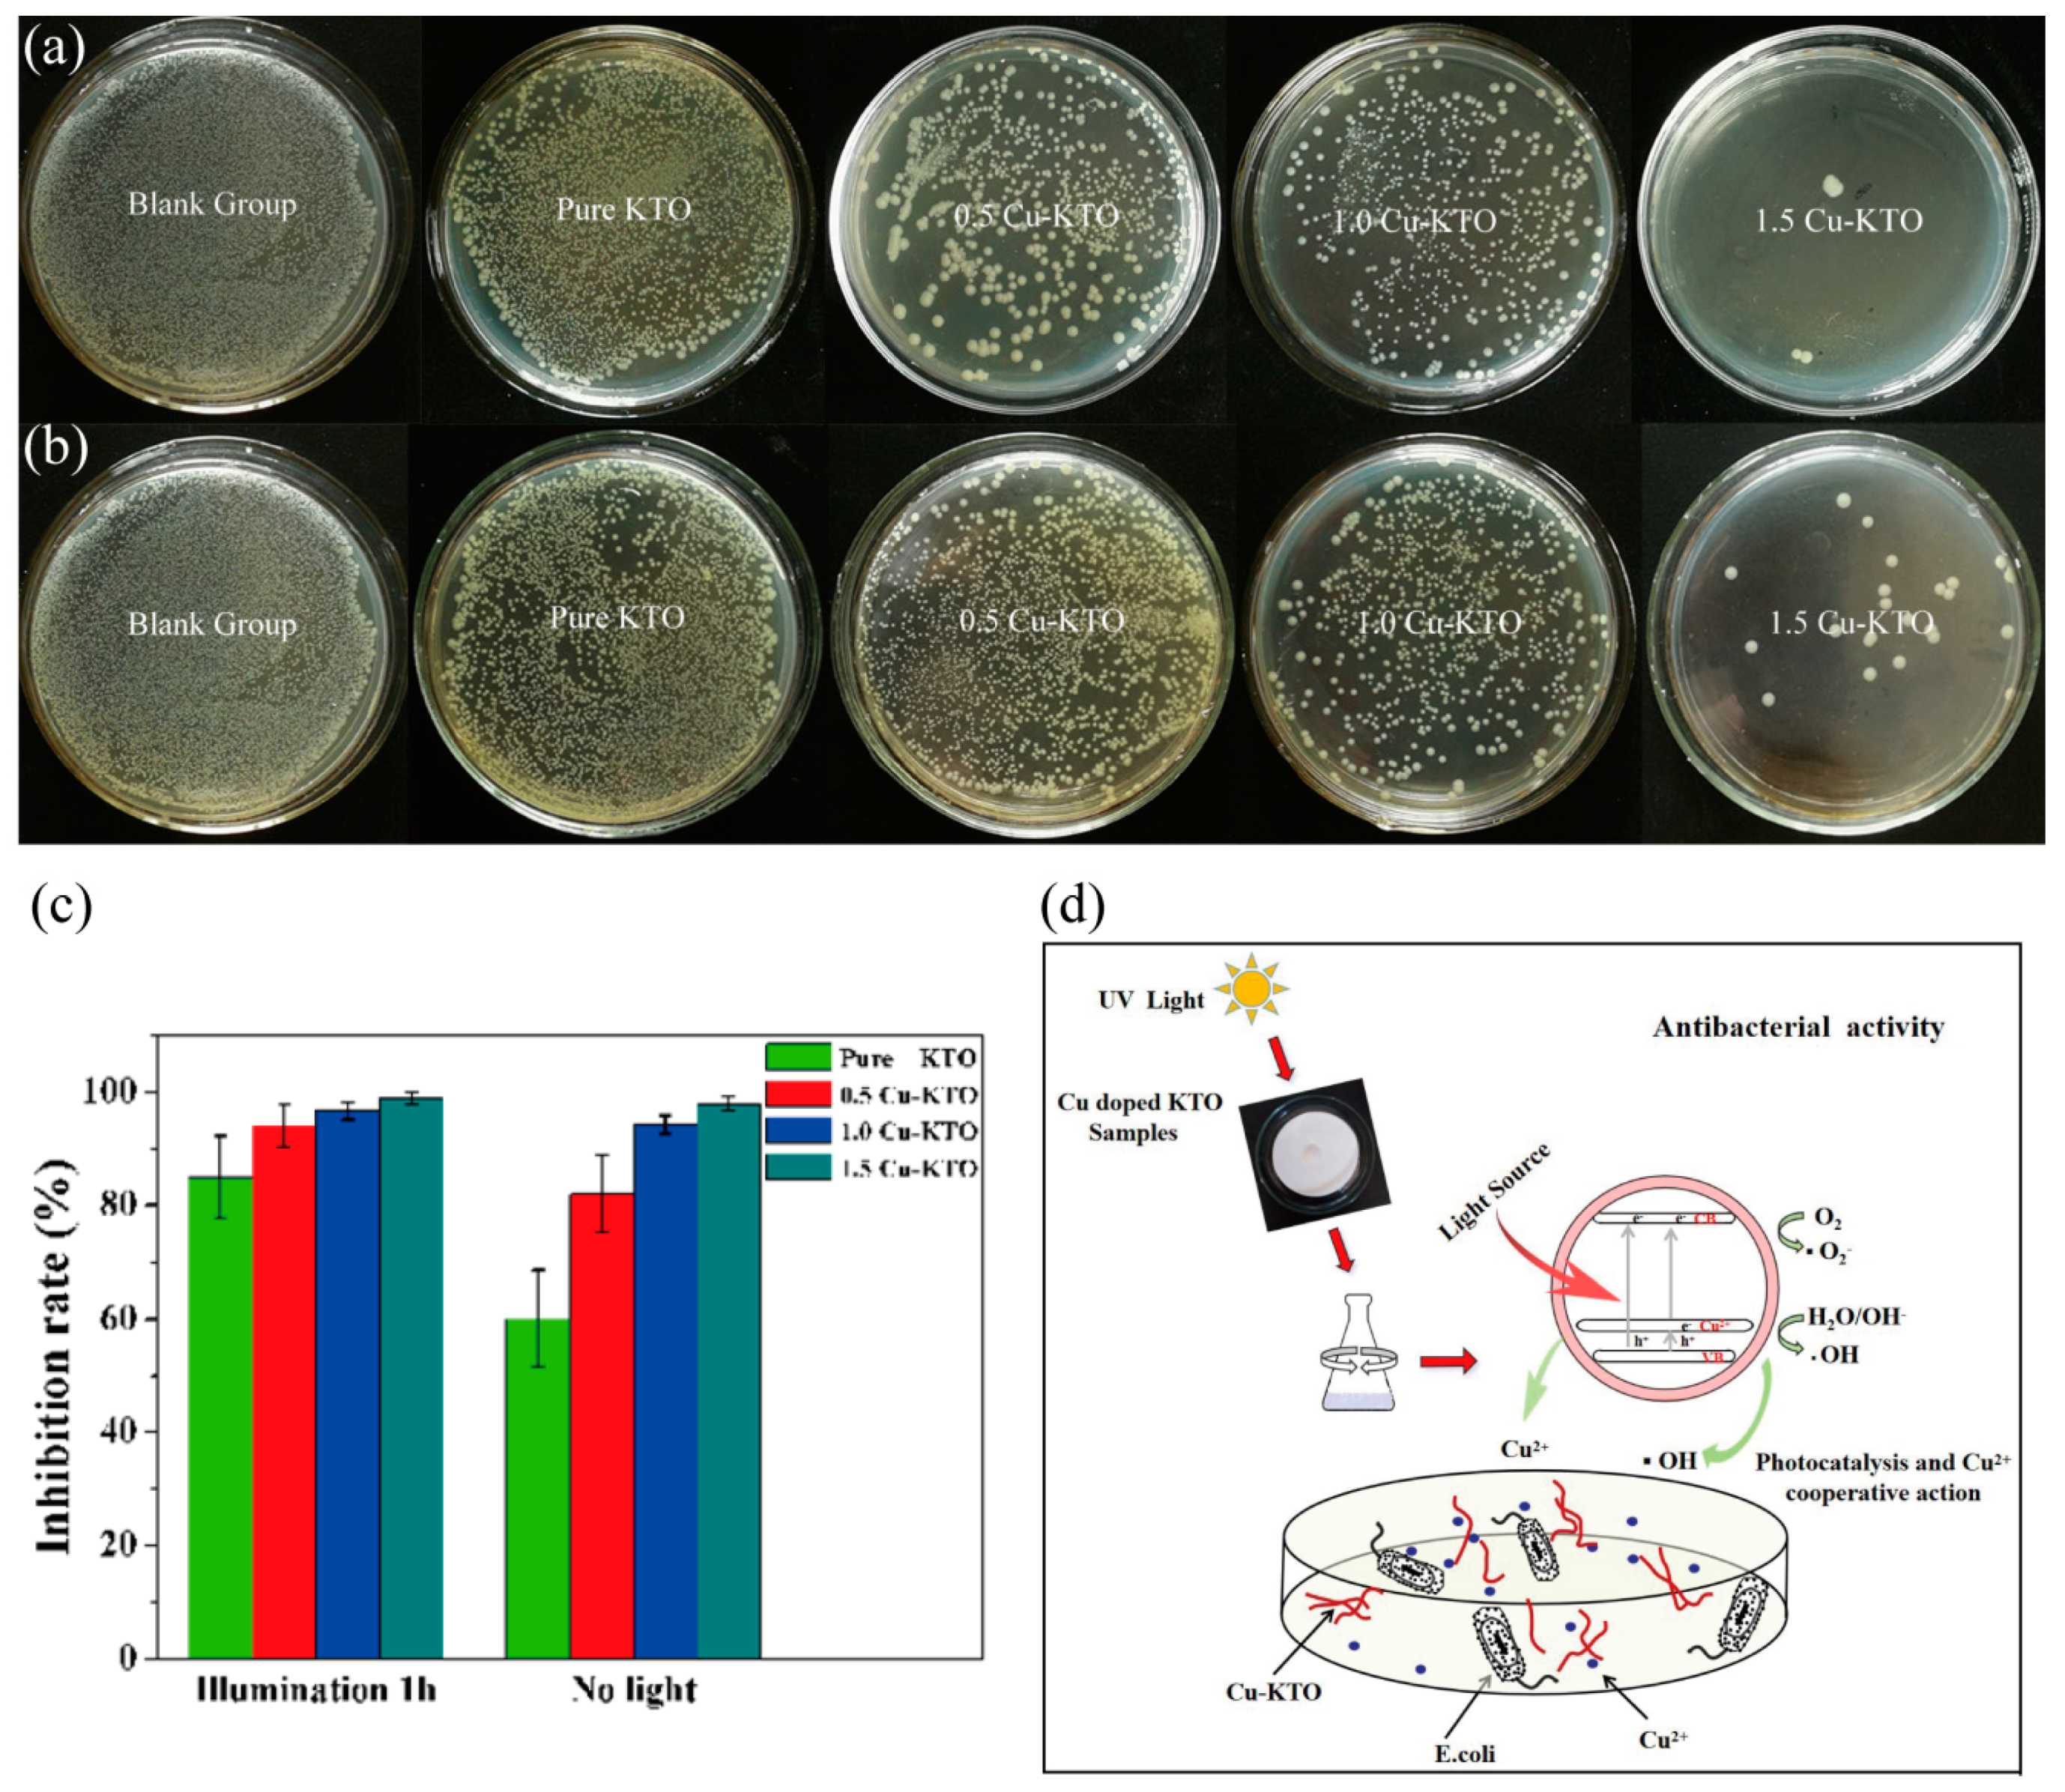
Crystals 10 00400 g007 Crystals 10 00400 g007

Enhanced Photocatalytic and Antibacterial Activities of K2Ti6O13 Nanowires Induced by Copper Doping
Abstract
1. Introduction
2. Materials and Methods
2.1. Synthesis of Materials
2.2. Characterization
2.3. Photocatalytic Experiments
2.4. Antibacterial Activity Tests
3. Results and Discussion
3.1. Microstructure
3.2. Optical Properties
3.3. Photocatalytic Properties
3.4. Antibacterial Properties
4. Conclusions
Author Contributions
Funding
Acknowledgments
Conflicts of Interest
References
- Zhao, D.; Wu, X. Nanoparticles assembled SnO2 nanosheet photocatalysts for wastewater purification. Mater. Lett. 2017, 210, 354–357. [Google Scholar] [CrossRef]
- Batista, L.M.B.; Dos Santos, A.J.; Silva, D.R.; Alves, A.P.D.; Garcia-Segura, S.; Martinez-Huitle, C.A. Solar photocatalytic application of NbO2OH as alternative photocatalyst for water treatment. Sci. Total Environ. 2017, 596, 9–86. [Google Scholar]
- Zubair, M.; Daud, M.; Mckay, G.; Shehzad, F. Recent progress in layered double hydroxides (LDH)-containing hybrids as adsorbents for water remediation. Appl. Clay Sci. 2017, 143, 79–92. [Google Scholar] [CrossRef]
- Liu, X.J.; Lei, G.; Wei, L.; Wang, X.Z.; Feng, L. Layered double hydroxide functionalized textile for effective oil/water separation and selective oil adsorption. ACS Appl. Mater. Interfaces 2015, 7, 791–800. [Google Scholar] [CrossRef] [PubMed]
- Cataldo, S.; Lazzara, G.; Massaro, M.; Muratore, N.; Pettignano, A.; Riela, S. Functionalized halloysite nanotubes for enhanced removal of lead(II) ions from aqueous solutions. Appl. Clay Sci. 2018, 156, 87–95. [Google Scholar] [CrossRef]
- Yang, S.; Wang, L.; Zhang, W. Enhanced adsorption of Congo red dye by functionalized carbon nanotube/mixed metal oxides nanocomposites derived from layered double hydroxide precursor. Chem. Eng. J. 2015, 5, 315–321. [Google Scholar] [CrossRef]
- Fujishima, A.; Honda, K. Electrochemical Photolysis of water at a semiconductor electrode. Nature 1972, 238, 37–38. [Google Scholar] [CrossRef]
- Shekofteh, G.M.; Habibi, Y.A.; Abitorabi, M. Magnetically separable nanocomposites based on ZnO and their applications in photocatalytic processes: A review. CRC Crit. Rev. Environ. Control 2018, 48, 806–857. [Google Scholar] [CrossRef]
- Pang, Y.L.; Lim, S.; Ong, H.C.; Chong, W.T. Research progress on iron oxide-based magnetic materials: Synthesis techniques and photocatalytic applications. Ceram. Int. 2016, 42, 9–34. [Google Scholar] [CrossRef]
- Jia, W.; Jia, B.; Qu, X. Towards a highly efficient simulated sunlight driven photocatalyst: A case of heterostructured ZnO/ZnS hybrid structure. Dalton Trans. 2013, 3, 14178–14187. [Google Scholar] [CrossRef]
- Sathishkumar, S.; Parthibavarman, M.; Sharmila, V.; Karthik, M. A facile and one step synthesis of large surface area SnO2 nanorods and its photocatalytic activity. J. Mater. Sci. Technol. 2017, 28, 1–5. [Google Scholar] [CrossRef]
- Wang, M.; Guo, P.; Chai, T.Y.; Xie, Y.; Han, J.; You, M. Effects of Cu dopants on the structures and photocatalytic performance of cocoon-like Cu-BiVO4 prepared via ethylene glycol solvothermal method. J. Alloys Compd. 2017, 691, 8–14. [Google Scholar] [CrossRef]
- Bakar, S.A.; Ribeiro, C. Nitrogen-doped titanium dioxide: An overview of material design and dimensionality effect over modern applications. J. Photoch. Photobiol. C 2016, 27, 1–29. [Google Scholar] [CrossRef]
- Hitam, C.N.C.; Jalil, A.A. A review on exploration of Fe2O3 photocatalyst towards degradation of dyes and organic contaminants. J. Environ. Manag. 2020, 258, 110050. [Google Scholar] [CrossRef]
- Hussain, M.; Ceccarelli, R.; Marchisio, D.L. Synthesis characterization, and photocatalytic application of novel TiO2 nanoparticles. Chem. Eng. J. 2010, 157, 45–51. [Google Scholar] [CrossRef]
- Ma, S.; Li, R.; Lv, C. Facile synthesis of ZnO nanorod arrays and hierarchical nanostructures for photocatalysis and gas sensor applications. J. Hazard. Mater. 2011, 192, 730–740. [Google Scholar] [CrossRef]
- Liu, H.; Dong, X.N.; Li, G.J. Solvothermal synthesis and photocatalysis of SnO2 nanocrystal microspheres. Adv. Mater. Res. 2011, 412, 40–43. [Google Scholar] [CrossRef]
- Karunakaran, C.; Senthilvelan, S. Photocatalysis with ZrO2: Oxidation of aniline. J. Mol. Catal. A Chem. 2005, 233, 1–8. [Google Scholar] [CrossRef]
- Hazra, C.; Kundu, D.; Chaudhari, A. Biogenic synthesis, characterization, toxicity and photocatalysis of zinc sulfide nanoparticles using rhamnolipids from Pseudomonas aeruginosa BS01 as capping and stabilizing agent. J. Chem. Technol. Biot. 2013, 88, 1039–1048. [Google Scholar] [CrossRef]
- Fujishima, A.; Zhang, X.; Tryk, D.A. TiO2 photocatalysis and related surface phenomena. Surf. Sci. Rep. 2008, 63, 515–582. [Google Scholar] [CrossRef]
- Verbruggen, S.W. TiO2 photocatalysis for the degradation of pollutants in gas phase: From morphological design to plasmonic enhancement. J. Photochem. Photobiol. C 2015, 24, 64–82. [Google Scholar] [CrossRef]
- Yahya, N.; Aziz, F.; Jamaludin, N.A.; Mutalib, M.A.; Ismail, A.F.; Salleh, W.N.W. A review of integrated photocatalyst adsorbents for wastewater treatment. J. Environ. Chem. Eng. 2018, 6, 7411–7425. [Google Scholar] [CrossRef]
- Kim, D.H.; Nikles, D.E.; Brazel, C.S. Synthesis and Characterization of Multifunctional Chitosan-MnFe2O4 Nanoparticles for Magnetic Hyperthermia and Drug Delivery. J. Mater. 2010, 3, 4051–4065. [Google Scholar] [CrossRef] [PubMed]
- He, G.; Meng, Q.; Zhao, X.; He, C.; Zhou, P.; Duan, C. A new copper (II) selective fluorescence probe based on naphthalimide: Synthesis, mechanism and application in living cells. Inorg. Chem. Commun. 2016, 65, 28–31. [Google Scholar] [CrossRef]
- Dou, Y.; Liu, H.; Peng, J.; Li, M.; Yang, F. A green method for preparation of CNT/CS/Ag NP composites and evaluation of their catalytic performance. J. Mater. Sci. 2016, 51, 1–10. [Google Scholar] [CrossRef]
- Moongraksathum, B.; Shang, J.Y.; Chen, Y.W. Photocatalytic antibacterial effectiveness of Cu-doped TiO2 thin film prepared via the peroxo sol-gel method. Catalysts 2018, 8, 352. [Google Scholar] [CrossRef]
- Pelaez, M.; Nolan, N.T.; Pillai, S.C. A review on the visible light active titanium dioxide photocatalysts for environmental applications. Appl. Catal. B Environ. 2012, 125, 331–349. [Google Scholar] [CrossRef]
- Bouras, P.; Stathatos, E.; Lianos, P. Pure versus metal-ion-doped nanocrystalline titania for photocatalysis. Appl. Catal. B Environ. 2007, 73, 51–59. [Google Scholar] [CrossRef]
- Thida, S.N.; Lek, S.; Rungrote, K. Photocatalytic activity enhancement of Dy-doped TiO2 nanoparticles hybrid with TiO2 (B) nanobelts under UV and fluorescence irradiation. Curr. Appl. Phys. 2020, 20, 249–254. [Google Scholar]
- Poonam, Y.; Pravin, K.D.; Surendar, T. Metal and non-metal doped metal oxides and sulfides. Green Photocatal. 2020, 3, 89–132. [Google Scholar]
- Wu, M.C.; Wu, P.Y.; Lin, T.H. Photocatalytic performance of Cu-doped TiO2 nanofibers treated by the hydrothermal synthesis and air-thermal treatment. Appl. Surf. Sci. 2018, 430, 390–398. [Google Scholar] [CrossRef]
- Xu, L.Q.; Li, C. Environmentally friendly growth of single-crystalline K2Ti6O13 nanoribbons from kcl flux. Mater. Charact. 2010, 61, 245–248. [Google Scholar] [CrossRef]
- Wang, B.L.; Chen, Q.; Wang, R.H.; Peng, L.M. Synthesis and characterization of K2Ti6O13 nanowires. Chem. Phys. Lett. 2003, 376, 726–731. [Google Scholar] [CrossRef]
- Meng, X.; Wang, D.; Liu, J.; Lin, B.; Fu, Z. Effects of titania different phases on the microstructure and properties of K2Ti6O13 nanowires. Solid State Commun. 2006, 137, 146–149. [Google Scholar] [CrossRef]
- Qi, Y.M.; Geng, X.Y.; Ma, B.H. In vitro hemolytic properties assessment of K2Ti6O13 nanowires. J. Nanoeng. Nanosyst. 2015, 229, 201–205. [Google Scholar] [CrossRef]
- Shim, J.P.; Lee, H.K.; Park, S.G.; Lee, J.S. The synthesis of potassium hexatitanate and manufacturing alkaline fuel cell matrix. Synth. Met. 1994, 71, 2261–2262. [Google Scholar] [CrossRef]
- Zhang, X.; Tang, S.; Zhai, L. A simple molten salt method to synthesize single-crystalline potassium titanate nanobelts. Mater. Lett. 2009, 63, 887–889. [Google Scholar] [CrossRef]
- Zhang, J.; Wang, Y.A.; Yang, J. Microwave-assisted synthesis of potassium titanate nanowires. Mater. Lett. 2006, 60, 3015–3017. [Google Scholar] [CrossRef]
- Garay, R.G.; Torres, M. Photocatalytic performance of K2Ti6O13 whiskers to H2 evolution and CO2 Photo-reduction. J. Nat. Gas Chem. 2019, 37, 18–28. [Google Scholar]
- Wang, Q.; Guo, Q.; Li, B. Low temperature synthesis and characterization of substitutional Na-modified K2Ti6O13 nanobelts with improved photocatalytic activity under UV irradiation. RSC Adv. 2015, 5, 66086–66095. [Google Scholar] [CrossRef]
- Chen, H.L.; Lu, H.Y.; Qi, Y.M.; Jin, P. The electronic structure and optical properties of K2Ti6O13 doped with transition metal Fe or Ag. Chin. J. Chem. Phys. 2018, 31, 318–324. [Google Scholar] [CrossRef]
- Qi, Y.M.; Chen, H.L.; Jin, P.; Lu, H.Y.; Cui, C.X. First-principles study of electronic structure and optical properties of Mn and Cu doped potassium hexatitanate (K2Ti6O13). Acta Phys. Sin. 2018, 67, 067101. [Google Scholar]
- Yan, L.; Li, Q.; Chi, H.; Qiao, Y.; Zhang, T.; Zheng, F. One-pot synthesis of acrylate resin and ZnO nanowires composite for enhancing oil absorption capacity and oil-water separation. Adv. Compos. Lett. 2018, 1, 567–576. [Google Scholar] [CrossRef]
- Raut, A.V.; Yadav, H.M.; Gnanamani, A.; Pushpavanam, S.; Pawar, S.H. Synthesis and characterization of chitosan-TiO2: Cu nanocomposite and their enhanced antimicrobial activity with visible light. Colloid Surf. B 2016, 148, 566–575. [Google Scholar] [CrossRef] [PubMed]
- Yang, X.J.; Wang, S.; Sun, H.M.; Wang, X.B.; Lian, J.S. Preparation and photocatalytic performance of Cu-doped TiO2 nanoparticles. Trans. Nonferrous Met. Soc. 2015, 25, 504–509. [Google Scholar] [CrossRef]
- Gladis, P.H.; Iliana, E.; Medina, R.; Juan Antonio, L.A.; Sandra, E.R. Evaluation of the photocatalytic activity of copper doped TiO2 nanoparticles for the purification and/or disinfection of industrial effluents. Catal. Today 2019, 341, 37–44. [Google Scholar]
- Lopez, R.; Gomez, R.; Llanos, M.E. Photophysical and photocatalytic properties of nanosized copper-doped titania sol-gel catalysts. Catal. Today 2010, 148, 103–108. [Google Scholar] [CrossRef]
- Zhang, W.J.; Li, Y.; Zhu, S.L.; Wang, F.H. Copper doping in titanium oxide catalyst film prepared by DC reactive magnetron sputtering. Catal. Today. 2004, 93–95, 589–594. [Google Scholar] [CrossRef]
- Yu, L.; Yuan, S.; Shi, L.; Zhao, Y.; Fang, J. Synthesis of Cu2+ doped mesoporous titania and investigation of its photocatalytic ability under visible light. Microporous Mesoporous Mater. 2010, 134, 108–114. [Google Scholar] [CrossRef]
- Luo, Z.; Cetegen, S.A.; Miao, R.; Jiang, T.; Chen, S.Y.; Jafari, T. Structure–property relationships of copper modified mesoporous TiO2 materials on alkyne homocoupling reactions. J. Catal. 2016, 338, 94–103. [Google Scholar] [CrossRef]
- Nada, A.A.; Bekheet, M.F.; Viter, R.; Miele, P.; Roualdes, S.; Bechelany, M. BN/GdxTi(1−x)O(4−x)/2 nanofibers for enchanced photocatalytic hydrogen production under visible light. Appl. Catal. B Environ. 2019, 251, 76–86. [Google Scholar] [CrossRef]
- Ying, L.; Xu, Z.; Chu, Y. Cu2O nanocrystals/TiO2 microspheres film on a rotating disk containing long-afterglow phosphor for enhanced round-the-clock photocatalysis. Appl. Catal. B Environ. 2018, 224, 239–248. [Google Scholar]
- Chen, W.T.; Jovic, V.; Sun, W.H. The role of CuO in promoting photocatalytic hydrogen production over TiO2. Int. J. Hydrogen Energy 2013, 38, 15036–15048. [Google Scholar] [CrossRef]
- Klein, J.C.; Li, C.P.; Hercules, D.M.; Black, J.F. Decomposition of copper compounds in X-ray photoelectron spectrometers. Appl. Spectrosc. 1984, 8, 729–734. [Google Scholar] [CrossRef]
- Xu, B.; Dong, L.; Chen, Y. Influence of CuO loading on dispersion and reduction behavior of CuO/TiO2 (anatase) system. J. Chem. Soc. Faraday Trans. 1998, 94, 1905–1909. [Google Scholar] [CrossRef]
- Lee, S.Y.; Mettlach, N.; Nguyen, N.; Sun, Y.M.; White, J.M. Copper oxide reduction through vacuum annealing. Appl. Surf. Sci. 2003, 206, 102–109. [Google Scholar] [CrossRef]
- Zhu, H.; Dong, L.; Chen, Y. Effect of titania structure on the properties of its supported copper oxide catalysts. J. Colloid Interface Sci. 2011, 357, 497–503. [Google Scholar] [CrossRef]
- Sathe, A.; Peck, M.A.; Balasanthiran, C.; Langell, M.A.; Rioux, R.M.; Hoefelmeyer, J.D. X-ray photoelectron spectroscopy of transition metal ions attached to the surface of rod-shape anatase TiO2 nanocrystals. Inorg. Chim. Acta 2014, 422, 8–13. [Google Scholar] [CrossRef]
- Ye, C.; Zhang, J.; Chen, F. Synthesis and Characterization of Nitrogen-Doped TiO2 nano photocatalyst with High Visible Light Activity. J. Phys. Chem. 2017, 111, 6976–6982. [Google Scholar]
- Xu, J.N.; Liu, Q.; Lin, S.F.; Cao, W.B. One-step synthesis of nanocrystalline N-doped TiO2 powders and their photocatalytic activity under visible light irradiation. Res. Chem. Intermediat. 2013, 39, 1655–1664. [Google Scholar] [CrossRef]
- Garzon, R.A.; Zuñiga, I.C.; Quiroga, G.E. Immobilization of doped TiO2 nanostructures with Cu or inside of macroporous silicon using the solvothermal method: Morphological, structural, optical and functional properties. Ceram. Int. 2020, 46, 1137–1147. [Google Scholar] [CrossRef]
- Xue, X.; Ji, W.; Mao, Z.; Mao, H.; Wang, Y.; Wang, X. Raman investigation of nanosized TiO2: Effect of crystallite size and phonon confinement. J. Phys. Chem. C 2012, 116, 8792–8797. [Google Scholar] [CrossRef]
- Mashary, F.S.; Castro, S.; Silva, A.F.; Felix, J.F. Effect of growth techniques on the structural, optical and electrical properties of indium doped TiO2 thin films. J. Alloys Compd. 2018, 766, 194–203. [Google Scholar] [CrossRef]
- Choudhury, B.; Dey, M.; Choudhury, A. Defect generation, d-d transition, and band gap reduction in Cu-doped TiO2 nanoparticles. Int. Nano Lett. 2013, 3, 25. [Google Scholar] [CrossRef]
- Dong, F.; Wang, H.Q.; Wu, Z.B.; Qiu, J.F. Marked enhancement of photocatalytic activity and photochemical stability of N-doped TiO2 nanocrystals by Fe3+/Fe2+ surface modification. J. Colloid Interface Sci. 2010, 343, 200–208. [Google Scholar] [CrossRef] [PubMed]
- Zhu, J.; Ren, J.; Hu, Y.N.; Bian, Z.F.; Li, H.X. Nanocrystalline Fe/TiO2 visible photocatalyst with a mesoporous structure prepared via a nonhydrolytic sol-gel route. J. Phys. Chem. 2007, 111, 18965–18969. [Google Scholar]
- Pollard, A.J.; Brennan, B.; Tyler, B.J.; Sean, M.P. Quantitative characterization of defect size in graphene using Raman spectroscopy. Appl. Phys. Lett. 2014, 105, 253107.1–253107.5. [Google Scholar] [CrossRef]
- Guo, N.G.; Zhou, Z.F. Size, shape, and temperature dependence of the phonon relaxation dynamics of cdse nanocrystals. Chem. Phys. Lett. 2013, 585, 167–170. [Google Scholar] [CrossRef]
- Huang, S.; Xu, Y.; Xie, M.; Liu, Q.; Xu, H.; Zhao, Y. A Z-scheme magnetic recyclable Ag/AgBr@CoFe2O4 photocatalyst with enhanced photocatalytic performance for pollutant and bacterial elimination. RSC Adv. 2017, 7, 30845–30854. [Google Scholar] [CrossRef]
- Yoon, H.J.; Choi, Y.I.; Jang, E.S. Graphene, charcoal, ZnO, and ZnS/BiOX (X = Cl, Br, and I) hybrid microspheres for photocatalytic simulated real mixed dye treatments. J. Ind. Eng. Chem. 2015, 32, 137–152. [Google Scholar] [CrossRef]
- Wu, Y.Q.; Zhou, S.S.; He, T.; Jin, X.Y.; Lun, L.Y. Photocatalytic activities of ZnWO4 and Bi@ ZnWO4 nanorods. Appl. Surf. Sci. 2019, 484, 409–413. [Google Scholar] [CrossRef]
- Funda, S.; Meltem, A.; Nadir, K.; Esin, B.; Ertğrul, A.; Hikmet, S. Photocatalytic antibacterial performance of Sn4+-doped TiO2 thin films on glass substrate. J. Hazard. Mater. 2009, 162, 1309–1316. [Google Scholar]
- Rtimi, S.; Giannakis, S.; Sanjines, R.; Pulgarin, C.; Bensimon, M.; Kiwi, J. Insight on the photocatalytic bacterial inactivation by co-sputtered TiO2–Cu in aerobic and anaerobic conditions. Appl. Catal. B Environ. 2016, 182, 277–285. [Google Scholar] [CrossRef]
- Yadav, H.M.; Otari, S.V.; Koli, V.B.; Mali, S.S.; Hong, C.K.; Pawar, S.H.; Delekar, S.D. Preparation and characterization of copper-doped anatase TiO2 nanoparticles with visible light photocatalytic antibacterial activity. J. Photochem. Photobiol. A Chem. 2014, 280, 32–38. [Google Scholar] [CrossRef]
- Gerard, C.; Bordeleau, L.J.; Barralet, J. The stimulation of angiogenesis and collagen deposition by copper. Biomaterials 2010, 31, 824–831. [Google Scholar] [CrossRef]
- Ram, K.S.; Kannan, S. Synthesis, structural analysis, mechanical, antibacterial and hemolytic activity of Mg2+ and Cu2+ co-substitutions in β-Ca3(PO4)2. Mater. Sci. Eng. C 2014, 45, 530–538. [Google Scholar]

© 2020 by the authors. Licensee MDPI, Basel, Switzerland. This article is an open access article distributed under the terms and conditions of the Creative Commons Attribution (CC BY) license (http://creativecommons.org/licenses/by/4.0/).
Share and Cite
Zhang, W.; Wang, X.; Ma, Y.; Wang, H.; Qi, Y.; Cui, C. Enhanced Photocatalytic and Antibacterial Activities of K2Ti6O13 Nanowires Induced by Copper Doping. Crystals 2020, 10, 400. https://doi.org/10.3390/cryst10050400
Zhang W, Wang X, Ma Y, Wang H, Qi Y, Cui C. Enhanced Photocatalytic and Antibacterial Activities of K2Ti6O13 Nanowires Induced by Copper Doping. Crystals. 2020; 10(5):400. https://doi.org/10.3390/cryst10050400
Chicago/Turabian StyleZhang, Weiwei, Xin Wang, Yuanhui Ma, Haoran Wang, Yumin Qi, and Chunxiang Cui. 2020. "Enhanced Photocatalytic and Antibacterial Activities of K2Ti6O13 Nanowires Induced by Copper Doping" Crystals 10, no. 5: 400. https://doi.org/10.3390/cryst10050400
APA StyleZhang, W., Wang, X., Ma, Y., Wang, H., Qi, Y., & Cui, C. (2020). Enhanced Photocatalytic and Antibacterial Activities of K2Ti6O13 Nanowires Induced by Copper Doping. Crystals, 10(5), 400. https://doi.org/10.3390/cryst10050400
